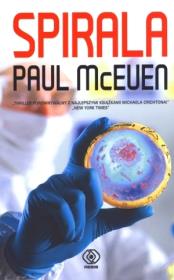
Okładka książki Spirala

Spirala
Autor:
McEuen Paul
Wydawca:
Rebis
wysyłka: niedostępny
ISBN:
9788375105001
EAN:
9788375105001
Oprawa:
Miękka ze skrzydełkami
Język:
polski
Seria:
Thriller
Format:
12.8x19.7cm
Liczba stron:
400
Rok wydania:
2011
(0) Sprawdź recenzje
36% rabatu
22,92 zł
Cena detaliczna:
35,90 zł
dodaj do schowka
koszty dostawy
Najniższa cena z ostatnich 30 dni: 22,92 zł
Opis produktuZasady bezpieczeństwa
Jest marzec 1946 roku. Liam Connor, młody biolog, trafia na pokład amerykańskiego pancernika na Oceanie Spokojnym. Jest świadkiem szokującej sceny: Amerykanie zrzucają bombę jądrową na własny okręt. Okazuje się, że załoga jest zainfekowana wyprodukowaną przez Japończyków w tajnej Jednostce 731 bronią biologiczną, która doprowadza ofiary do morderczego szału i zabija je w ciągu kilku dni. Wydaje się, że wraz ze zniszczeniem okrętu zagrożenie minęło, ale - o czym Amerykanie nie wiedzą - pozostał jeszcze jeden pojemnik z Uzumaki. I jest jeszcze jeden ochotnik, którego samobójcza misja wciąż trwa... Mija ponad sześćdziesiąt lat i Liam Connor, teraz noblista i emerytowany profesor Uniwersytetu Cornella, ponownie musi się zmierzyć z upiorami przeszłości. Jemu, jego współpracownikom i rodzinie grozi skrajne niebezpieczeństwo. A Uzumaki może znowu zagrozić światu. Wystarczy jeden zarodnik śmiertelnego grzyba. `Technothriller porównywalny z najlepszymi książkami Michaela Crichtona` - New York Times `Oszałamiające osiągnięcie`- Booklist
x

Uwaga!!!
Ten produkt jest zapowiedzią. Realizacja Twojego zamówienia ulegnie przez to wydłużeniu do czasu premiery tej pozycji. Czy chcesz dodać ten produkt do koszyka?
TAK
NIE

Wybierz wariant produktu
|








